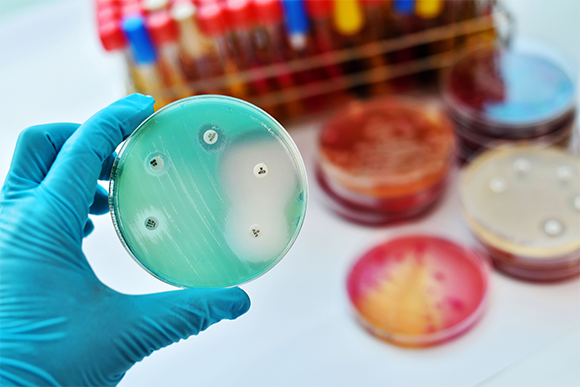
בדיקת עמידות לאנטיביוטיקה בצלחת פטרי | Shutterstock, Jarun Ontakrai

מה חדש?
- ההשמנה שמתחילה בראש
- האם אבותינו הקדמונים בקרקעית הים יכלו לנוע כמו ברדלס?
- המגפה הנסתרת
- קרח הולך ונעלם
- שנת הכריש
ההשמנה שמתחילה בראש
החלבון FKBP51 קושר בעבר להפרעות נפשיות המושפעות ממתח, ואף לדיכאון, אך מנגנון פעולתו לא היה ברור. כעת גילו חוקרים מגרמניה כי החלבון הזה חיוני לתפקודו של ההִיפּוֹתַלָמוּס, אזור במוח האחראי בין השאר על ויסות מערכות הגוף במטרה לשמור על איזון גופני.
החוקרים גילו כי מחסור ב-FKBP51 בהיפותלמוס מביא לעלייה במשקל ולצריכה מוגברת של אוכל. הם גם הראו שפעולתו של החלבון נחוצה לקיומו של תהליך האוטופגיה, כלומר פירוק ומיחזור של רכיבים תאיים שאינם נחוצים עוד. החוקרים משערים שלחץ נפשי משפיע על בריאות התאים ועל תפקודם. הפעילות של החלבון בתאי המוח והשפעתו על תהליך האוטופגיה מגינה כנראה על התאים מנזקי הלחץ הנפשי.
המחקר נערך על עכברים, ולא על בני אדם, אך הוא מעלה על הפרק מנגנון אפשרי שמקשר בין לחץ, יציבות מוחית, והשמנה. בעקבות הממצא, ייתכן שבעתיד טיפולים בלחץ נפשי ובתופעות הנובעות ממנו יתמקדו בין השאר בעידוד מושכל של תהליך האוטופגיה. למאמר המלא (באנגלית).

השפעתו של החלבון על תהליך האוטופגיה מגינה כנראה על התאים מנזקי הלחץ הנפשי. אילוסטרציה של אוטופאגיה בתוך ליזוזום | Kateryna Kon,Shutterstock
טל פישר
האם אבותינו הקדמונים בקרקעית הים יכלו לנוע כמו ברדלס?
סלמנדרות, אפילו כשהן מנסות לרוץ, נעות באופן שונה מאוד מסוס דוהר או מברדלס. צורת התנועה שלהן היא סימטרית, כמו בהליכה: בכל זוג רגליים, כשרגל ימין נמצאת מלפנים הרגל השמאלית נמצאת מאחור, ולהפך. מדענים שיערו שאופן התנועה הזה אפיין את בעלי החיים הקדמונים שעברו מהים ליבשה. על פי אותה השערה, רק בשלב הרבה יותר מאוחר, כשהופיעו היונקים, התפתחה גם תנועה א-סימטרית, כגון תנועת הדהרה האופיינית ליונקים יבשתיים מהירים רבים, שבה הגפיים הקדמיות נעות יחד והגפיים האחוריות נעות יחד.
מחקר חדש גילה כי ההשערה הזאת כנראה איננה נכונה. במחקר ניסו להסיק מה היה האופן שבו נעו בעלי החוליות הקדומים ביותר. לשם כך אספו מידע על אופן התנועה של 308 בעלי חוליות בני ימינו, ובהם יונקים, זוחלים ואפילו דגים. בעזרת הדמיות ממוחשבות של אילנות היוחסין האבולוציוניים של היצורים הללו הגיעו החוקרים למסקנה שתנועות סימטריות ותנועות א-סימטריות התפתחו ואבדו לסירוגין לאורך מיליוני שנים במשפחות נפרדות של מינים חיים. יתר על כן, נראה כי כבר האב הקדמון של כל בעלי החוליות, שנע על קרקעית הים שנים רבות לפני ראשית תהליך המעבר ליבשה, פיתח תנועה א-סימטרית. לקריאה בהרחבה (באנגלית), למחקר המלא (באנגלית).

כבר האב הקדמון של כל בעלי החוליות פיתח תנועה א-סימטרית, כמו זו של הברדלס. ברדלס רץ | slowmotiongli, Shutterstock
יפתח דיבון
המגפה הנסתרת
מחקר גדול ומקיף מצא כי מספר האנשים שמתים מזיהומים של חיידקים עמידים לאנטיביוטיקה גבוה כמעט כפליים מהערכות שהיו מקובלות עד כה. החוקרים ריכזו נתונים מרשומות של בתי חולים, מעבדות, מחקרים וניסויים קליניים מ-204 מדינות וטריטוריות, על מקרי מוות בשנת 2019 שהיו קשורים ל-23 חיידקים מחוללי מחלות ול-88 שילובים שלהם עם תרופות אנטיביוטיות.
באמצעות מודלים סטטיסטיים העריכו החוקרים כי 1.27 מיליון בני אדם נפטרו ברחבי העולם בשנה זאת ישירות מזיהומים של חיידקים עמידים, מתוך 4.95 מיליון בני אדם סך הכול שמתו מהחיידקים או מסיבות עקיפות הקשורות להם. רוב מקרי המוות נבעו משישה מינים של חיידקים עמידים. הבעיה חמורה במיוחד במדינות עניות, והתמותה הגבוהה ביותר מחיידקים עמידים נרשמה במדינות מערב אפריקה שמדרום לסהרה. שיעור התמותה הנמוך ביותר נמצא באוסטרליה.
הנתונים החדשים חושפים את ההיקף העצום של בעיית העמידות לאנטיביוטיקה ומדגישים את הצורך הדחוף בפעולה מיידית לבלימת התופעה. למחקר המלא (באנגלית). לכתבה באתר.
מספר האנשים שמתים מזיהומים של חיידקים עמידים לאנטיביוטיקה גבוה כמעט כפליים מהערכות שהיו מקובלות עד כה. בדיקת עמידות לאנטיביוטיקה בצלחת פטרי | Shutterstock, Jarun Ontakrai
אילת זאוברמן
קרח הולך ונעלם
כיפת הקרח בקוטב הצפוני מצטמקת מהר משחשבנו עד כה. מדידות חדשות העלו כי תוך 18 שנים בלבד הנפח של כיפת הקרח המכסה את האוקיינוס הארקטי בעונת החורף הצטמצם בשליש, או בכ-6,000 קילומטרים מעוקבים. בנוסף, עוביה של שכבת קרח הים הרב-שנתי, שנותרת קפואה גם בחודשי הקיץ, הצטמצם בשנת 2021 בכחצי מטר לעומת שנת 2019, ירידה של 16 אחוז. הנתונים האלה, שהתקבלו באמצעות לוויין חדיש, נמוכים בכעשרים אחוז לעומת ההערכות הקודמות לגבי היקפה של כיפת הקרח בקוטב הצפוני.
הצטמקות כיפת הקרח נובעת מהעלייה בטמפרטורה העולמית, שמקורה בגזי החממה הנפלטים לאטמוספרה מפעילות האדם. חוקרי אקלים מעריכים כי עד שנת 2050 צפוי קרח הים בקוטב הצפוני להיעלם לחלוטין במהלך הקיץ. לשינוי הזה עלולות להיות השלכות משמעותיות על מאזן החזר קרינת השמש של כדור הארץ, ועל דפוס זרמי האוקיינוסים העולמי. למאמר המלא (באנגלית).

הצטמקות כיפת הקרח נובעת מהעלייה בטמפרטורה העולמית, שמקורה בגזי החממה הנפלטים לאטמוספרה. קרחונים נשברים סמוך לקוטב הצפוני | Shutterstock, Avatar_023
אור אליאסון
שנת הכריש

כרישים לא ישנים? הם דווקא כן. כריש מהמין Cephaloscyllium isabellum | ויקיפדיה, Materialscientist